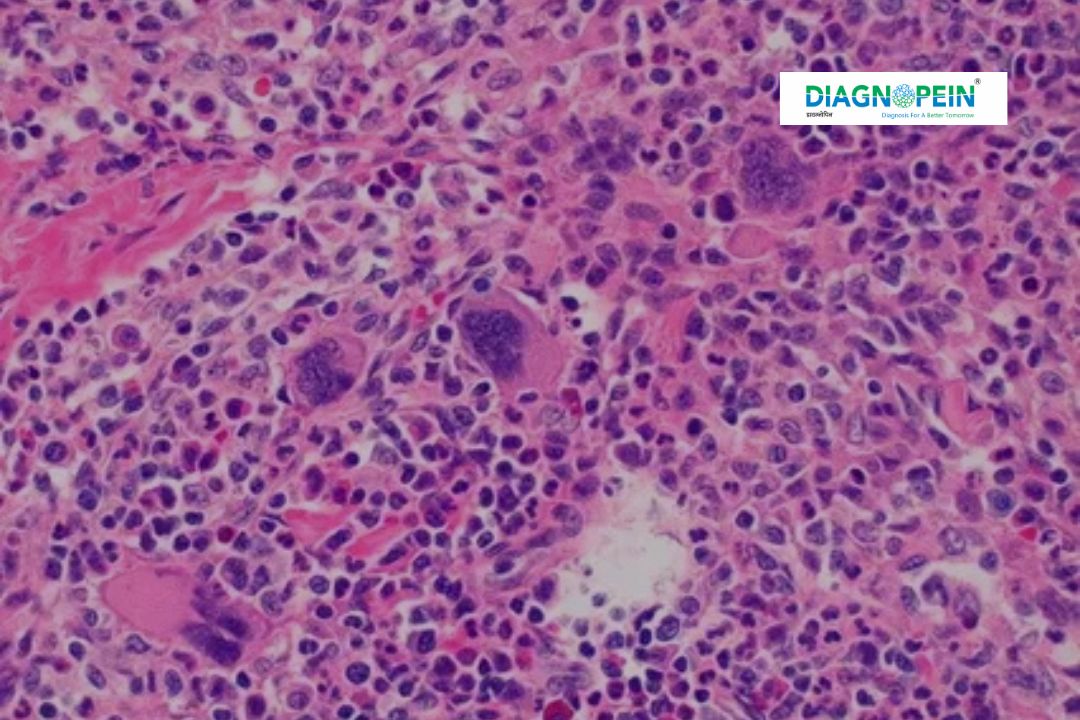

Diagnopein offers precise HPE Lymph Node testing in Karad, helping detect infections, cancers, and immune-related diseases through expert histopatho


The HPE Lymph Node test (Histopathological Examination of Lymph Node) is an advanced diagnostic procedure used to evaluate lymph node tissues under a microscope. It helps identify conditions like tuberculosis, lymphoma, metastatic cancer, and chronic infections by studying the microscopic structure of lymph node cells. At Diagnopein Karad, our pathology specialists perform this test using high-resolution imaging and modern staining techniques to provide accurate and timely reports.
This test plays a crucial role in differentiating between benign and malignant lymph node enlargements, helping doctors plan the right treatment and follow-up care. Lymph nodes act as key filters in the immune system, so any abnormality detected early through HPE can guide lifesaving interventions.
The importance of the HPE Lymph Node test lies in its ability to provide a clear picture of the underlying cause of lymph node enlargement. For patients with unexplained swelling, fever, or weight loss, this test helps in confirming or ruling out serious diseases.
Benefits of HPE Lymph Node:
Early detection of cancerous and non-cancerous disorders.
Helps diagnose lymphoma, tuberculosis, and autoimmune diseases.
Supports doctors in treatment planning and prognosis prediction.
Accurate identification of infection type and tissue changes.
With Diagnopein’s advanced lab infrastructure in Karad, patients can expect highly reliable results and expert pathology opinions within a short turnaround time.
At Diagnopein Karad, the HPE Lymph Node test process follows strict medical and ethical standards. The procedure involves:
Sample Collection: A small tissue sample from an enlarged lymph node is collected using a biopsy or surgical excision.
Tissue Processing: The sample undergoes fixation, dehydration, embedding, and sectioning.
Microscopic Examination: Pathologists examine stained slides under a microscope to identify changes in cell structure or abnormal growth.
Report Generation: Detailed histopathology reports highlight the diagnosis, ensuring precise guidance for further treatment.
All procedures are handled with utmost care to maintain the integrity of the biopsy sample and accuracy of the results.
When performing HPE Lymph Node analysis, the following key parameters are assessed:
Cell morphology: Shape, size, and uniformity of lymphoid cells.
Tissue architecture: Evaluation of follicular pattern, necrosis, fibrosis, or granuloma formation.
Presence of malignant cells: Assessment for lymphoma or metastatic cancer.
Signs of infection: Tuberculous or inflammatory changes identified through special stains.
Immune cell response: Evidence of hyperplasia or other immune-related activity.
The combination of these diagnostic indicators allows pathologists to establish a precise diagnosis and detect any disease at an early stage.
Experienced histopathologists and modern equipment.
Quick, accurate, and ethical diagnostic reporting.
Convenient sample collection and consultation support.
Trusted by leading oncologists and clinicians in Karad.
Affordable testing with transparent pricing and expert guidance.
Risks are minimal but may include bleeding, bruising, or infection at the biopsy site. For excisional biopsies, there may also be a risk of scarring or reaction to anesthesia.
For Fine Needle Aspiration, a thin needle is inserted into the lymph node to collect cells. In an excisional biopsy, a small incision is made to remove a part or the entire lymph node. The sample is then sent to a laboratory for histopathological examination.
For an excisional biopsy, your doctor may ask you to avoid eating or drinking a few hours before the procedure. For Fine Needle Aspiration, little to no special preparation is usually needed.
The HPE Lymph test involves minor discomfort depending on the method used for sample collection. Fine Needle Aspiration is minimally invasive and typically less painful than an excisional biopsy, which may require local or general anesthesia.